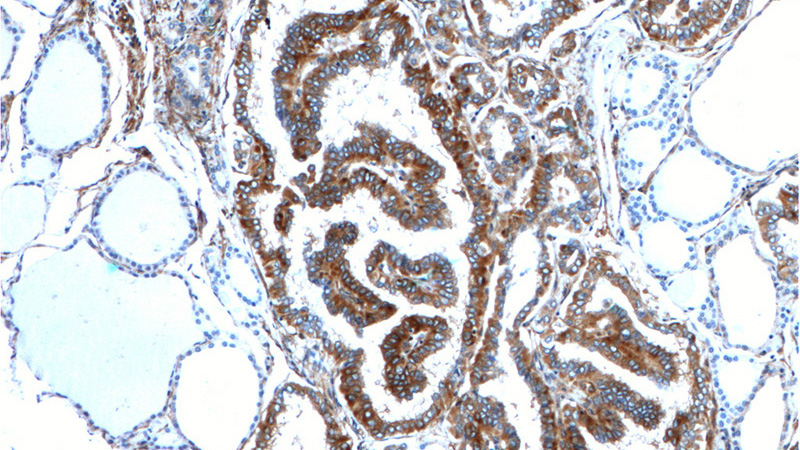
Immunohistochemistry of paraffin-embedded human thyroid cancer tissue slide using Catalog No:113846(PRKCA Antibody) at dilution of 1:200 (under 10x lens).

-
Product Name
PKC alpha antibody
- Documents
-
Description
PKC alpha Rabbit Polyclonal antibody. Positive IHC detected in human thyroid cancer tissue. Positive IF detected in NIH/3T3 cells. Positive WB detected in Jurkat cells, NIH/3T3 cells. Positive IP detected in NIH/3T3 cells. Observed molecular weight by Western-blot: 77 kDa
-
Tested applications
ELISA, WB, IP, IHC, IF
-
Species reactivity
Human, Mouse; other species not tested.
-
Alternative names
AAG6 antibody; PKC A antibody; PKC alpha antibody; PKCA antibody; PRKACA antibody; PRKCA antibody; Protein kinase C alpha type antibody; protein kinase C antibody; alpha antibody
-
Isotype
Rabbit IgG
-
Preparation
This antibody was obtained by immunization of PKC alpha recombinant protein (Accession Number: AK055431). Purification method: Antigen affinity purified.
-
Clonality
Polyclonal
-
Formulation
PBS with 0.02% sodium azide and 50% glycerol pH 7.3.
-
Storage instructions
Store at -20℃. DO NOT ALIQUOT
-
Applications
Recommended Dilution:
WB: 1:500-1:5000
IP: 1:500-1:5000
IHC: 1:20-1:200
IF: 1:20-1:200
-
Validations

Jurkat cells were subjected to SDS PAGE followed by western blot with Catalog No:113846(PRKCA antibody) at dilution of 1:1000

IP Result of anti-PRKCA (IP:Catalog No:113846, 4ug; Detection:Catalog No:113846 1:1000) with NIH/3T3 cells lysate 1600ug.
Immunohistochemistry of paraffin-embedded human thyroid cancer tissue slide using Catalog No:113846(PRKCA Antibody) at dilution of 1:200 (under 10x lens).

Immunohistochemistry of paraffin-embedded human thyroid cancer tissue slide using Catalog No:113846(PRKCA Antibody) at dilution of 1:200 (under 40x lens).

Immunofluorescent analysis of (-20oc Ethanol) fixed NIH/3T3 cells using Catalog No:113846(PRKCA Antibody) at dilution of 1:50 and Alexa Fluor 488-congugated AffiniPure Goat Anti-Rabbit IgG(H+L)
-
Background
Protein kinase C (PKC) is a family of serine- and threonine-specific protein kinases that can be activated by calcium and the second messenger diacylglycerol. PKC family members phosphorylate a wide variety of protein targets and are known to be involved in diverse cellular signaling pathways. PKC family members also serve as major receptors for phorbol esters, a class of tumor promoters. Each member of the PKC family has a specific expression profile and is believed to play a distinct role in cells. PRKCA is one of the PKC family members. This kinase has been reported to play roles in many different cellular processes, such as cell adhesion, cell transformation, cell cycle checkpoint, and cell volume control. Knockout studies in mice suggest that this kinase may be a fundamental regulator of cardiac contractility and Ca(2+) handling in myocytes.
-
References
- Jiang L, Cui Y, Luan J, Zhou X, Zhou X, Han J. A comparative proteomics study on matrix vesicles of osteoblast-like Saos-2 and U2-OS cells. Intractable & rare diseases research. 2(2):59-62. 2013.
Related Products / Services
Please note: All products are "FOR RESEARCH USE ONLY AND ARE NOT INTENDED FOR DIAGNOSTIC OR THERAPEUTIC USE"
